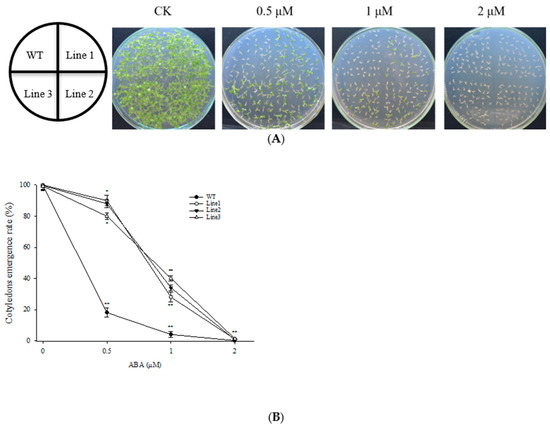

Abstract
The ubiquitination pathway has been found to regulate plant responses to environmental stress. However, the role of E3 ubiquitin ligase in desiccation tolerant moss has not yet been elucidated. Previous research has shown that the abscisic acid (ABA) signaling factor ScABI3 can significantly increase desiccation tolerance and reduce ABA sensitivity in the desert moss Syntrichia caninervis. In this study, we identified a RING-type E3 ubiquitin ligase, ScPRT1, and showed that ScABI3 can directly interact with ScPRT1 in vitro and in vivo. Furthermore, we found that the high expression of ScPRT1 can interfere with the transcription of ScABI3 under ABA treatment. Therefore, we speculate that ScPRT1 may degrade ScABI3 through the ubiquitin-26S proteasome system and participate in ABA-dependent signaling in response to ABA-insensitivity or desiccation tolerance in S. caninervis. The findings from our study may enrich our knowledge of the role of E3 ubiquitin ligase in desiccation tolerance and lay a theoretical foundation for an in-depth study of the relationship between ubiquitination modification and ABA signal transduction under environmental stress.
1. Introduction
Plants, as sessile organisms, must adapt in situ to changing environmental conditions. Over evolutionary history, plants have evolved a set of adaptive mechanisms to effectively deal with abiotic and biotic stressors. One such mechanism, ubiquitination, a protein post-translational modification, plays an important role in diverse aspects of eukaryotic cell regulation, especially in the plant stress response [1,2]. Ubiquitination provides flexibility and diversity in response to different environmental conditions by modulating protein turnover and homeostasis through the addition of one or more ubiquitins in different configurations [3]. Conjugation occurs via the sequential actions of three enzyme families which ultimately couple ATP hydrolysis to isopeptide bond formation: the E1 ubiquitin-activating enzymes, the E2 ubiquitin-conjugating enzymes, and the E3 ubiquitin-protein ligases [4]. Specifically, E3 ubiquitin ligase plays a critical role in the ubiquitin proteasome system (UPS) by selecting appropriately from a myriad of candidate proteins during ubiquitination, thus regulating the plants’ response to abiotic stress [5,6].
The plant hormone abscisic acid (ABA) can catalyze the binding of ubiquitin to target proteins through E3 ligase, at the same time, E3 ligase can participate in the regulation of ABA stability, and play a key role in ABA signal perception and regulation [7]. ABSCISIC ACID INSENSITIVE 3 (ABI3), a transcription factor found in a variety of plants, is a key regulator of ABA signal transduction. As a regulatory gene, ABI3 can together with interacting factors, respond to various phytohormone signaling pathways and participate in regulating plant growth and stress response [8,9,10]. Specifically, ABI3 can bind to the regulatory elements in the promoter region of the target gene through its B1, B2, and B3 domains, and thus regulate the physiological and biochemical processes of plants by activating or inhibiting the transcriptional activity of the target gene [11,12,13]. The relationship between ABI3 and E3 ubiquitin ligase has been studied in many plants. For example, the RING-type E3 ligase AIP2 negatively regulates ABA signaling through the degradation of ABI3 in Arabidopsis thaliana [14]. Similarly in wheat, the AIP2 homolog TaAIP2 negatively regulates ABA signaling and controls seed panicle germination by polyubiquitination of TaABI3 [15]. In rice, the AIP2 homologous protein OsDSG1 can interact with and degrade OsABI3 by ubiquitination in order to regulate seed germination and abiotic stress [16]. In addition, ABI3-regulated downstream transcription factor DREB2A is also a target protein of RING-type E3 ubiquitinates DRIP1 and DRIP2, and negatively regulates the water stress response [17]. FUS3, in the same subgroup of ABI3, is also regulated by AIP2 ubiquitination and plays a role in cotyledon development and flowering in A. thaliana [18].
S. caninervis, a desert moss that is naturally exposed to unpredictable cycles of dehydration and rehydration, can tolerate severe desiccation. Amazingly, S. caninervis can lose up to 90% of its tissue water, and upon rehydration, recover and restore normal growth within 30 s [19,20]. This trait makes S. caninervis an ideal model for elucidating the molecular mechanisms of desiccation tolerance in non-vascular plants [21]. In our previous work, we cloned the ABI3 gene from S. caninervis, and found that ScABI3 transgenic A. thaliana had improved salt and drought tolerance, increased expression of stress-related genes, and reduced ABA sensitivity [22]. We performed yeast two-hybrid screening using the S. caninervis cDNA library as prey and ScABI3 as bait to investigate the interaction between ScABI3 and other proteins, the results showed that ScABI3 can interact with multiple proteins, including an E3 ubiquitin ligase.
Previous research has reported that ubiquitination modification modulates the ABA signaling pathway in vascular plants [23,24,25]. However, the specific role of E3 ubiquitin ligase in desiccation-tolerant moss is still unclear, and precisely how the ubiquitination modification modulates the ABI3 transcription factor is unexplored. Here, we isolated a putative C3HC4-RING ubiquitin E3 ligase PRT1 (PROTEOLYSIS1) from S. caninervis, and revealed that ScPRT1 physically interacts with ScABI3 in vitro and in vivo. Moreover, we showed that overexpression of ScABI3 significantly increased the cotyledon emergence rates by over 80% compared with WT, and ScPRT1 antagonism against ScABI3 transcription during ABA treatment. This study provides new insights into the modulation mechanism of ubiquitination modification on the ABA signaling pathway in desiccation-tolerant moss.
2. Materials and Methods
2.1. Gene Cloning and Bioinformatics Analysis
The PRT1 gene was cloned by the RT-PCR method from the genome of S. caninervis [21]. Multiple sequence alignments and phylogenetic trees were constructed using the DNAMAN software ver. 5.2.2.0 (Lynnon BioSoft, San Ramon, CA, USA) and the BLASTN program (NCBI, Bethesda, MD, USA).
2.2. Analysis of ScABI3 Transgenic A. thaliana Germination under ABA Treatment
ScABI3 transgenic A. thaliana plants were obtained as described by Zhang et al. [22]. Seeds of wild-type Columbia 0 (WT) and three independent transgenic lines (line 1, line 2, and line 3) were surface sterilized and sown on MS agar medium (controls) or MS agar medium supplemented with 0.5, 1.0, or 2.0 µM ABA as treatments. Cotyledon emergence rates were scored after 7 days of 16/8 h light/dark cycles at 23 °C with a light intensity of 100 µmol photons m−2 s−1. All experiments have been replicated a minimum of three times.
2.3. Yeast Two-Hybrid Assay
The truncated sequence of ScABI3 was used to construct the pGBKT7-ScABI3 yeast expression vector as bait because the full-length sequence has an autoactivation domain [22]. ScPRT1 which was verified to have no autoactivation was used to construct the pGADT7-ScPRT1 yeast expression vector, as prey protein. A mixture of both vectors was transformed into the yeast strain AH109 by the lithium acetate method following the Yeast Protocols Handbook (Clontech Laboratories, Mountain View, CA, USA), plated on the SD/-Trp-Leu or SD/-Trp-Leu-His selection medium and incubated at 28 °C for 3 days to identify the transformants. We selected colonies from SD/-Trp-Leu-His and plated them on SD/-Trp-Leu-His-Ade medium again for further selection. The interaction was confirmed by plating on SD/-Trp-Leu-His-Ade medium containing X-α-gal. The combination of pGBKT7-p53+pGADT7-largeT was used as a positive control and the combination of pGBKT7-laminC+pGADT7-largeT empty vector was used as a negative control. Three independent experiments were performed and similar results were obtained.
2.4. Pull-Down Assays
The coding sequence (CDS) of ScABI3 was cloned into the pD2P vector with a GFP tag. The CDS of ScPRT1 was cloned into the pD2P vector fused with a His-tag. The recombinant proteins were expressed in cell-free protein expression according to the protocol of Protein Factory 1.0 (Kangma-Healthcode, Shanghai, China). GFP and GFP-tagged ScABI3 were purified by GFP-trap beads according to the manufacturer’s protocol (GE Healthcare, Marlborough, MA, USA). His and His-tagged ScPRT1 protein were purified by Ni-NTA beads (Qiagen, Hilden, Germany). Subsequently, 5 μg samples of ScABI3-GFP or GFP were incubated with 5 μg samples of ScPRT1-His in 500 μL pull-down buffer (150 mM NaCl, 20 mM Tris, 1 mM phenyl-methylsulfonyl fluoride, 0.2% Triton X-100, 1% protease inhibitor cocktail, pH 8.0) at 4 °C for 2 h. The beads were washed thoroughly with the pull-down buffer and proteins were eluted from the beads by boiling at 95 °C with 30 μL sodium dodecyl sulfate-polyacrylamide gel electrophoresis (SDS-PAGE) loading buffer for 10 min and then separated by SDS-PAGE. Immunoblot assays were performed using the anti-His (Abmart, Berkeley Heights, NJ, USA) and anti-GFP (Abmart, Berkeley Heights, NJ, USA) antibodies, respectively.
2.5. Bimolecular Fluorescence Complementation (BiFC) Assays
The BiFC vector was designed based on the split fluorescent protein (YFP). Full-length coding cDNA sequences of ScABI3 and ScPRT1 were cloned into the pCAMBIA1300-35S-YC155 and pCAMBIA1300-35S-NY173 vectors, respectively, which were then transformed into Agrobacterium tumefaciens strain GV3101. The strain was incubated in LB medium overnight and resuspended in infiltration buffer (10 mM MgCl2, 10 mM MES and 100 µM acetosyringone) to a final concentration of OD600 = 0.4 and placed at room temperature (25 °C) for 2–3 h before infiltration into Nicotiana benthamiana leaves. Infiltration was achieved by forcing a solution of suspended A.tumefaciens cells into leaves, while still attached to the plant, by applying positive pressure with a syringe as described by Kudla and Bock [26]. Plants with infiltrated leaves were incubated in the greenhouse for 3 days under 25 °C, 150 µmol photons m−2 s−1, and RH = 25%. The YFP fluorescent signal in the leaf was examined under a confocal microscope (LSM700, Carl Zeiss, Oberkochen, Germany) with 514 nm excitation. Three replicates were applied to each treatment.
2.6. Expression Analysis of ScABI3 and ScPRT1 Genes under Different Abiotic Stress Treatments in S. caninervis
To evaluate the expression levels of ScABI3 and ScPRT1, 10–12 gametophores were collected at different time points, for a total of 50–60 dry gametophore samples. For ABA treatments, dry samples were fully hydrated for 24 h, transferred to new Petri plates containing filter papers saturated with 100 µM ABA, and incubated for 0, 0.5, 1, 2, 4, 6, 8, 12, and 24 h at room temperature (25 °C, 150 µmol photons m−2 s−1, and RH = 25%). For dehydration treatments, dry gametophores were fully hydrated for 24 h and air-dried for the same processing times as the ABA treatments at room temperature. For rehydration treatments, dry gametophores were transferred to Petri plates containing filter papers saturated with 8 mL of filtered water and incubated for the same processing times as the ABA treatments, at room temperature. For salt stress, dry samples were fully hydrated for 24 h, transferred to new Petri plates containing filter papers saturated with 250 µM NaCl, and incubated for the same processing times as the ABA treatments, at room temperature.
All harvested samples were flash-frozen in liquid N2 and stored at −80 °C prior to RNA extraction. Total RNA was extracted using E.Z.N.A. Plant RNA Kit (Omega Bio-Tek, Norcross, GA, USA). cDNA was synthesized using random hexamer primers with PrimeScript RT reagent Kit (Takara Bio, Shiga, Japan). The qRT-PCR primers were designed using the Primer Premier 5.0 software (Premier Biosoft, San Francisco, CA, USA) (Table 1). qRT-PCR was performed using the SYBR Premix Ex Taq II (TIi RNaseH Plus, Takara, Bio, Shiga, Japan). The fluorescence intensity was measured with a CFX96 Real-Time System (Bio-Rad, Hercules, CA, USA). The target gene expression levels were normalized using the α-tubulin2 gene as an internal reference [27]. The relative abundance of the transcripts compared to the reference gene was calculated according to the 2−ΔΔCt method [28]. Each reaction was performed in triplicate.

Table 1.
Primer information for qRT-PCR.
2.7. Statistical Analysis
Statistical analyses were performed using SPSS version 18.0 (SPSS Inc., Chicago, IL, USA). Data were compared by one-way analysis of variance (ANOVA), and differences were considered statistically significant at p < 0.05 and substantially significant at p < 0.01.
3. Results
3.1. Multiple Sequence Alignment and Phylogenetic Analysis of ScPRT1
We obtained the genomic sequence of the ScPRT1 protein from the genome of the desiccation-tolerant moss S. caninervis. This sequence contains a 711 bp open-reading frame, encoding a protein containing 236 amino acid residues. Multiple sequence alignments of the ScPRT1 ORF with PRT1 ORF of 20 species from NCBI indicate that the ScPRT1 belongs to the C3HC4-RING ubiquitin E3 ligase PRT1 and contains the highly conserved cysteine and histidine functional domain regions (Figure 1A). Phylogenetic analysis indicated that PRT1 proteins form two groups based on overall protein structure and that ScPRT1 clustered in the same branch as the Physcomitrella patens PRT1 which indicated a similar ancestry or function (Figure 1B).

Figure 1.
Multiple sequence alignment and phylogenetic analysis of ScPRT1. (A) Amino acid sequence alignment of ScPRT1 and closely related PRT1 from other plant species. ScPRT1 (S. caninervis), PpPRT1 (P. patens, XM_024525392.1), AtPRT1 (A. thaliana, AY080799.1), OsPRT1 (Oryza sativa, XM_015767241.2), MtPRT1 (Medicago truncatula, XM_003604918.4), ZmPRT1 (Zea mays, XM_020538608.2), GmPRT1 (Glycine max, XM_006602468.4), BhPRT1 (Benincasa hispida, XM_039021813.1), CrPRT1 (Capsella rubella, XM_006297601.2), CsPRT1 (Cucumis sativus, XM_004139587.3), EgPRT1 (Eucalyptus grandis, XM_010038525.3), GhPRT1 (Gossypium hirsutum, XM_016840815.2), JrPRT1 (Juglans regia, XM_018985173.2), LsPRT1 (Lactuca sativa, XM_023899275.2), PdPRT1 (Phoenix dactylifera, XM_008786960.4), PaPRT1 (Populus alba, XM_035060044.1), QsPRT1 (Quercus suber, XM_024035664.1), SoPRT1 (Saccharum officinarum, MT747433.1), SvPRT1 (Setaria viridis, XM_034746023.1), SbPRT1 (Sorghum bicolor, XM_002454141.2). Multiple sequence alignments were conducted using the DNAMAN software. Common identical amino acid residues are shown with a dark background and similar residues are shown with a light background. The C3HC4-RING domains are indicated by the blue box. (B) Phylogenetic relationships between ScPRT1 and other reported PRT1 from P. patens and higher plants. The phylogenetic tree was constructed using the neighbor-joining method in MEGA 5.0.
3.2. Overexpression of ScABI3 Reduced the Sensitivity of Seeds under ABA Treatment
Three independent transgenic overexpression lines (T3) with the highest accumulation of ScABI3 (Line 1, Line 2, and Line 3) were chosen for seed germination assays (Figure 2A). The cotyledon emergence rates of WT and transgenic lines were not significantly different in the control MS medium. In contrast, cotyledon emergence rates were severely inhibited for WT seeds by both 0.5 and 1 µM ABA, approximately 18% and 4%, respectively, but were only slightly inhibited in the three transgenic lines, from 80 to 90% and 28 to 40%, respectively, for the 0.5 and 1 µM ABA treatments (Figure 2B).
Figure 2.
Germination assay of WT and transgenic A. thaliana under ABA treatment. (A) The germination of four lines on MS containing 0, 0.5, 1.0, and 2.0 µM ABA. (B) The cotyledon emergence rate according to A. The experiments have been repeated at least three times. * Indicates a significant difference (p < 0.05), and ** indicates a substantially significant difference between the transgenic line and WT (p < 0.01).
3.3. ScABI3 Interacts with ScPRT1 in Yeast Two-Hybrid Assays
We isolated ScABI3-interacting protein candidate ScPRT1 for further analysis and performed a one-by-one Y2H assay to confirm the interaction between ScABI3 and ScPRT1. The results revealed that ScABI3 could strongly interact with ScPRT1 in yeast (Figure 3).

Figure 3.
Interaction test by Y2H assay. The transformed cells were plated onto SD-T: -trp, SD-L: -leu; SD-TL: -trp, -leu; SD-TLH: -trp, -leu, -his; SD-TLHA: -trp, -leu, -his, -ade medium. The known pGBKT7-p53 + pGADT7-largeT vector was used as a positive control, and the pGBKT7-laminC + pGADT7-largeT vector was used as a negative control.
3.4. ScABI3 Interaction with ScPRT1 In Vitro by Pull-Down Assays
In this study, His-tagged ScPRT1 was immobilized on the Ni column and assayed for the ability to pull down the GFP-ScABI3 fusion protein. Pulldown results were analyzed by immunoblotting with anti-GFP and anti-His antibodies. As shown in the first lane of Figure 3, which shows the pulldown result compared to GFP only (lane 2), purified GFP-ScABI3 (lane 3), and purified His-ScPRT1 (lane 5), both His-ScPRT1 and GFP-ScABI3 bands were simultaneously present in the membrane. Further Western blot analysis detected another protein, which suggests that His-ScPRT1 can interact with GFP-ScABI3 directly in vitro (Figure 4).

Figure 4.
Pull-down assay shows that ScABI3 directly interacts with ScPRT1 in vitro. His-ScPRT1 was pulled down by GFP-ScABI3 immobilized on anti-GFP affinity beads or Ni-NTA magnetic agarose beads and analyzed by Western blotting using an anti-GFP or anti-His antibody. GFP-ScABI3 protein was incubated with protein extracts containing His-ScPRT1 and further immobilized with anti-GFP and anti-His antibodies.
3.5. ScABI3 Interaction with ScPRT1 by BiFC in N. benthamiana
To further characterize the interaction between ScABI3 and ScPRT1 in vivo, a BiFC assay was performed by co-infiltration of recombinant strain combination 35S::ScABI3-YC + 35S::ScPRT1-NY into N. benthamiana leaves to observe the fluorescence. As a result, a strong yellow fluorescent signal was observed on the nuclei of the epidermal cells when either of the above combinations was delivered into the tobacco plant, compared to no fluorescent signal in cells with any of the other combinations (Figure 5). This result verified that ScABI3 potentially interacted with ScPRT1 on the nuclei.

Figure 5.
BiFC assay shows that ScABI3 interacts with ScPRT1 in N. benthamiana leaf epidermal cells. ScABI3 was fused to the C-terminal fragment of YFP (YC) and ScPRT1 was fused to the N-terminal fragment of YFP (NY). The interaction between ScABI3-YC and NY or YC and ScPRT1-NY or YC and NY serves as the negative controls.
3.6. ScABI3 and ScPRT1 Expression Induced by Multiple Abiotic Stresses
Transcriptional expression of ScABI3 and ScPRT1 was analyzed after exposure to ABA, dehydration, rehydration, and salt treatment (Figure 6). Under ABA treatment, ScABI3 showed a modest upregulation with increasing time, with the highest expression level at 24 h (Figure 6A), showing only a 6-fold induction compared to 0 h. In contrast, ScPRT1 was significantly upregulated after 1 h and exhibited an almost 40-fold increase after 8 h of treatment followed by a gradual decline from 12 h to 24 h (but was still significantly higher than at 0 h). In response to desiccation treatment, the transcriptional level of ScABI3 was significantly induced after 4 h and increased to the highest value from 12 h to 24 h. The accumulation of ScPRT1 was significantly induced from 0.5 h, reaching a maximal value of more than seven times the value from 6 h to 8 h. Overall, the transcript abundance of ScPRT1 was higher at each point under desiccation tolerance, except for 24 h (Figure 6B). Under rehydration treatment, the transcripts of ScABI3 and ScPRT1 both showed significant accumulation at the beginning and then decreased with increasing time. ScABI3 abundance reached a maximal value of 3.0 times that of the control at 6 h. In contrast, the transcript abundance of ScPRT1 reached its maximal value of 2.4 times that of the control at 2 h (Figure 6C). Under NaCl treatment, the transcript abundance of ScABI3 had a 4.8-fold increase during 6–12 h of treatment, compared to the control condition. Meanwhile, the highest expression level of ScPRT1 was observed around 4–24 h with a greater than 6.0-fold increase compared with 0 h (Figure 6D).

Figure 6.
Expression patterns of ScABI3 and ScPRT1 in response to different stress treatments. (A) ABA, (B) dehydration, (C) rehydration, (D) NaCl treatment. The 2−ΔΔCT method was used in the qRT-PCR analysis, with α-tubulin as the internal reference gene and 0 h treatment as the control. Values are means ± SE of three replicates. * Indicates a significant difference (p < 0.05). ** Indicates a substantially significant difference (p < 0.01).
4. Discussion
The plant hormone ABA can activate diverse adaptive responses to unfavorable environments and is especially vital for desiccation tolerance acquisition [23,29]. The E3 ligases can interact with and degrade specific substrates by ubiquitination and are also involved in ABA signal transduction by diverse means [30]. For example, The RING-type E3 ligase SDIR1 is located upstream of ABI5, ABF3, and ABF4, which are positive regulators in ABA signal transduction. SDIR1 selectively regulates the expression of the downstream transcription factor ABI5 by affecting the stability of its substrate SDIRIP1, thereby regulating ABA-mediated seed germination and salt stress [6]. RING-type E3 ligases RGLG5 and RGLG1 release the blockade of ABA signaling by PP2C by regulating the degradation of PP2C protein and activating the ABA signaling pathway [31]. The SCF-type E3 ligase complex AtPP2-B11 can directly interact with and degrade SnRK2.3, negatively regulating the plant response to ABA [32]. U-box E3 ligases PUB12 and PUB13 can also interact with ABI1. When ABA and PYR1 are present at the same time, PUB12 and PUB13 can ubiquitinate ABI1 and participate in plant dehydration [33]. Plants overexpressing U-box E3 ligase PUB10 showed the phenotype of myc2 mutant, and under ABA treatment, PUB10 plants showed the phenotype of MYC2 overexpression, which indicated that PUB10 can degrade MYC2 through ubiquitination and negatively regulate ABA signaling [34].
E3 ligases modulate the activity and localization of key factors in the ABA signaling pathway by ubiquitination and thus affect the response of plants to ABA. Although a number of E3 ligases with positive and negative regulatory functions involved in the regulation of ABA signaling have been found in vascular plants, research on ubiquitination in non-vascular plants is still in its infancy. For example, the polyubiquitin chain-binding subunit (PpMCB1) is regarded as one of the first reported moss ubiquitin-initiating enzymes in P. patens, which can bind polyubiquitin chains and help modulate the plant hormone-mediated 26S proteasomal degradation pathway [35]. By studying the evolution of the protein COP1/SPA encoded by the E3 ligase complex CUL4s, it was found that the COP1 protein maintained functional conservation in P. patens, rice, and A. thaliana, while the SPA protein showed considerable variability across species. It is speculated that this variability may be related to the number of copies of coding genes in different species [36]. A U-box E3 ubiquitin ligase, PnSAG1, was cloned from the moss Pohlia nutans, which grows in extreme environments on the Antarctic continent. After overexpression of the gene in P. patens and A. thaliana, it exhibited ABA treatment and salt sensitivity to stress, which indicated that PnSAG1 is a negative regulator of the ABA and salt stress signaling pathways [37]. Importantly to our work, ABI3 represents the core machinery of the ABA signal pathway, and the desiccation tolerance response of moss is mediated by ABI3, with a mutation in this gene resulting in the loss of tolerance [9,38]. However, whether other proteins interact with ABI3 and regulate ABA signaling via ubiquitination in moss has not been clear.
In this study, we found that ectopic expression of the ScABI3 gene can reduce the ABA sensitivity of A. thaliana during seed germination (Figure 2). Further, we showed that a potential interaction existed between ScABI3 and ScPRT1, which was supported by in vitro pulldown and in vivo BiFC assays (Figure 3, Figure 4 and Figure 5). Moreover, we identified a representative RING ubiquitin ligase ScPRT1 from S. caninervis, which shares a relatively high similarity with other PRT1 proteins in other plants (Figure 1b). Belonging to the C3HC4-RING member of the RING-type E3 ligase with N-terminal rule PROTEOLYSIS1 (PRT1) (Figure 1a), it may lead to ubiquitination and degradation by recognizing the N-terminal residue of the target substrate [39]. qRT-PCR experiments confirmed that ScABI3 and ScPRT1 genes could be induced to express under desiccation, rehydration, and NaCl treatments, and the expression trends were relatively consistent (Figure 6B–D). In contrast, antagonistic expression patterns of ScABI3 and ScPRT1 were seen under ABA treatment (Figure 6A). Therefore, we hypothesize that the ABA-insensitive phenotype of ScABI3 transgenic plants is due to the ubiquitination and degradation of ScABI3 after binding to ScPRT1.
Based on our data, a possible model for the interaction between ScABI3 and ScPRT1 in response to ABA treatment is proposed (Figure 7). Briefly, under normal conditions, ScABI3 and ScPRT1 have similar expression levels, both WT and ScABI3 transgenic lines seeds germinate, used ABA treatment, and ScPRT1 is highly expressed and interacts with or ubiquitinates ScABI3, resulting in the low expression of ScABI3 and transgenic seed insensitivity to ABA. However, ubiquitination is a post-translational process of proteins degradation, the relationship between transcript levels increasing has not been proved, and the precise mechanism whereby ScPRT1 functions as an E3 ubiquitin ligase and modulates transcriptional activity of the ScABI3 remains unclear. Further studies are needed to identify the mechanism of ScPRT1 regulation of ABA-mediated signaling by ubiquitination, which will help to clarify how protein post-translational modification regulates the ABA and drought-signaling pathways in moss.

Figure 7.
A possible model for the interaction between ScABI3 and ScPRT1 in response to ABA treatment is proposed.
5. Conclusions
In summary, we targeted a RING-type E3 ubiquitin ligase ScPRT1 and proved that ScABI3 can directly interact with ScPRT1 using Yeast two-hybrid, Pull-down, and BiFC assays in S. caninervis. We found that the high expression of ScPRT1 can interfere with the transcription of ScABI3 under ABA treatment. Our findings enrich the knowledge of the role of E3 ubiquitin ligase and provide a valuable reference for the relationship between ubiquitination modification and ABA signal transduction in desiccation tolerance moss.
Author Contributions
Conceptualization, Y.Z. (Yigong Zhang) and D.Z.; methodology, J.Z.; experimental work, Y.Z. (Yi Zhang) and Y.Z. (Yigong Zhang); writing—original draft preparation, Y.Z. (Yigong Zhang) and J.Z.; writing—review and editing, J.Z. and Y.Z. (Yigong Zhang); supervision, D.Z. All authors have read and agreed to the published version of the manuscript.
Funding
This research was funded by The National Natural Science Foundation of China, grant number 31900270 and The Technology Training Project for Excellent Young Scholars of Xinjiang, grant number 2019Q014.
Institutional Review Board Statement
Not applicable.
Informed Consent Statement
Not applicable.
Data Availability Statement
Not applicable.
Conflicts of Interest
The authors declare no conflict of interest.
References
- Xu, F.Q.; Xue, H.A.-O. The ubiquitin-proteasome system in plant responses to environments. Plant Cell Environ. 2019, 42, 2931–2944. [Google Scholar] [CrossRef] [PubMed]
- Vierstra, R.D. The ubiquitin-26s proteasome system at the nexus of plant biology. Nat. Rev. Mol. Cell Biol. 2009, 10, 385–397. [Google Scholar] [CrossRef] [PubMed]
- Sadanandom, A.; Bailey, M.; Ewan, R.; Lee, J.; Nelis, S. The ubiquitin-proteasome system: Central modifier of plant signalling. New Phytol. 2012, 196, 13–28. [Google Scholar] [CrossRef] [PubMed]
- Smalle, J.; Vierstra, R.D. The ubiquitin 26s proteasome proteolytic pathway. Annu. Rev. Plant Biol. 2004, 55, 555–590. [Google Scholar] [CrossRef] [PubMed]
- Stone, S.L. Chapter three—Role of the ubiquitin proteasome system in plant response to abiotic stress. In International Review of Cell and Molecular Biology; Galluzzi, L., Ed.; Academic Press: Cambridge, MA, USA, 2019; Volume 343, pp. 65–110. [Google Scholar]
- Zhang, H.; Cui, F.; Wu, Y.; Lou, L.; Liu, L.; Tian, M.; Ning, Y.; Shu, K.; Tang, S.; Xie, Q. The ring finger ubiquitin e3 ligase sdir1 targets sdir1-interacting protein1 for degradation to modulate the salt stress response and aba signaling in arabidopsis. Plant Cell 2015, 27, 214–227. [Google Scholar] [CrossRef] [PubMed]
- Zhang, Y.; Yang, C.; Li, Y.; Zheng, N.; Chen, H.; Zhao, Q.; Gao, T.; Guo, H.; Xie, Q. Sdir1 is a ring finger e3 ligase that positively regulates stress-responsive abscisic acid signaling in arabidopsis. Plant Cell 2007, 19, 1912–1929. [Google Scholar] [CrossRef]
- Lin, J.-H.; Yu, L.; Xiang, C.-B. Arabidopsis nitrate regulated 1 acts as a negative modulator of seed germination by activating abi3 expression. New Phytol. 2019, 225, 835–847. [Google Scholar] [CrossRef]
- Khandelwal, A.; Cho, S.H.; Marella, H.; Sakata, Y.; Perroud, P.F.; Pan, A.; Quatrano, R.S. Role of aba and abi3 in desiccation tolerance. Science 2010, 327, 546. [Google Scholar] [CrossRef]
- Tomoi, T.; Kawade, K.; Kitagawa, M.; Sakata, Y.; Tsukaya, H.; Fujita, T. Quantitative imaging reveals distinct contributions of snrk2 and abi3 in plasmodesmatal permeability in physcomitrella patens. Plant Cell Physiol. 2020, 61, 942–956. [Google Scholar] [CrossRef]
- Yotsui, I.; Saruhashi, M.; Kawato, T.; Taji, T.; Hayashi, T.; Quatrano, R.; Sakata, Y. Abscisic acid insensitive3 regulates abscissic acid-responsive gene expression with the nuclear factor y complex through the actt-core element in physcomitrella patens. New Phytol. 2013, 199, 101–109. [Google Scholar] [CrossRef]
- Bedi, S.; Nag Chaudhuri, R. Transcription factor abi3 auto-activates its own expression during dehydration stress response. FEBS Lett. 2018, 592, 2594–2611. [Google Scholar] [CrossRef] [PubMed]
- Sengupta, S.; Ray, A.; Mandal, D.; Nag Chaudhuri, R. Abi3 mediated repression of rav1 gene expression promotes efficient dehydration stress response in arabidopsis thaliana. BBA-Gene Regul. Mech. 2020, 1863, 194582. [Google Scholar] [CrossRef] [PubMed]
- Zhang, X.; Garreton, V.F.; Chua, N.-H.; Chua, N.H. The aip2 e3 ligase acts as a novel negative regulator of aba signaling by promoting abi3 degradation. Genes Dev. 2005, 19, 1532–1543. [Google Scholar] [CrossRef] [PubMed]
- Gao, D.-Y.; Xu, Z.-S.; He, Y.; Sun, Y.-W.; Ma, Y.-Z.; Xia, L.-Q. Functional analyses of an e3 ligase gene aip2 from wheat in arabidopsis revealed its roles in seed germination and pre-harvest sprouting. J. Integr. Plant Biol. 2014, 56, 480–491. [Google Scholar] [CrossRef]
- Park, G.-G.; Park, J.-J.; Yoon, J.; Yu, S.-N.; An, G. A ring finger e3 ligase gene, oryza sativa delayed seed germination 1 (osdsg1), controls seed germination and stress responses in rice. Plant Mol. Biol. 2010, 74, 467–478. [Google Scholar] [CrossRef] [PubMed]
- Qin, F.; Sakuma, Y.; Tran, L.-S.; Maruyama, K.; Kidokoro, S.; Fujita, Y.; Fujita, M.; Umezawa, T.; Sawano, Y.; Miyazono, K.-I.; et al. Arabidopsis dreb2a-interacting proteins function as ring e3 ligases and negatively regulate plant drought stress-responsive gene expression. Plant Cell 2008, 20, 1693–1707. [Google Scholar] [CrossRef] [PubMed]
- Duong, S.; Vonapartis, E.; Li, C.-Y.; Patel, S.; Gazzarrini, S. The e3 ligase abi3-interacting protein2 negatively regulates fusca3 and plays a role in cotyledon development in arabidopsis thaliana. J. Exp. Bot. 2017, 68, 1555–1567. [Google Scholar] [CrossRef][Green Version]
- Pan, Z.; Pitt, W.G.; Zhang, Y.; Wu, N.; Tao, Y.; Truscott, T.T. The upside-down water collection system of Syntrichia caninervis. Nat. Plants 2016, 2, 16076. [Google Scholar] [CrossRef]
- Zhang, Y.; Mutailifu, A.; Zhang, Y.; Yang, H.; Zhang, D. Detection of abscisic acid and relative transcript abundance in syntrichia caninervis mitt. J. Bryol. 2021, 43, 376–383. [Google Scholar] [CrossRef]
- Silva, A.T.; Gao, B.; Fisher, K.; Mishler, B.; Ekwealor, J.; Stark, L.; Li, X.-S.; Zhang, D.; Bowker, M.; Brinda, J.; et al. To dry perchance to live: Insights from the genome of the desiccation-tolerant biocrust moss syntrichia caninervis. Plant J. 2020, 105, 1339–1356. [Google Scholar] [CrossRef]
- Zhang, Y.; Liu, X.; Zhang, K.; Zhang, D.; Guan, K. An abscisic acid insensitive3-like gene from the desert moss syntrichia caninervis confers abiotic stress tolerance and reduces aba sensitivity. Plant Cell Tissue Organ Cult. 2018, 133, 417–435. [Google Scholar] [CrossRef]
- Yu, F.; Wu, Y.; Xie, Q. Ubiquitin-proteasome system in aba signaling: From perception to action. Mol. Plant 2016, 9, 21–33. [Google Scholar] [CrossRef]
- Bueso, E.; Rodriguez, L.; Lorenzo-Orts, L.; Gonzalez-Guzman, M.; Sayas, E.; Munoz-Bertomeu, J.; Ibanez, C.; Serrano, R.; Rodriguez, P.L. The single-subunit ring-type e3 ubiquitin ligase rsl1 targets pyl4 and pyr1 aba receptors in plasma membrane to modulate abscisic acid signaling. Plant J. 2014, 80, 1057–1071. [Google Scholar] [CrossRef] [PubMed]
- Pan, W.; Lin, B.; Yang, X.; Liu, L.; Xia, R.; Li, J.; Wu, Y.; Xie, Q. The ubc27–airp3 ubiquitination complex modulates aba signaling by promoting the degradation of abi1 in arabidopsis. Proc. Natl. Acad. Sci. USA 2020, 117, 27694–27702. [Google Scholar] [CrossRef] [PubMed]
- Kudla, J.; Bock, R. Lighting the way to protein-protein interactions: Recommendations on best practices for bimolecular fluorescence complementation analyses. Plant Cell 2016, 28, 1002–1008. [Google Scholar] [CrossRef] [PubMed]
- Li, X.; Zhang, D.; Li, H.; Gao, B.; Yang, H.; Zhang, Y.; Wood, A.J. Characterization of reference genes for rt-qpcr in the desert moss syntrichia caninervis in response to abiotic stress and desiccation/rehydration. Front. Plant Sci. 2015, 6, 38. [Google Scholar] [CrossRef]
- Livak, K.J.; Schmittgen, T.D. Analysis of relative gene expression data using real-time quantitative pcr and the 2−δδct method. Methods 2001, 25, 402–408. [Google Scholar] [CrossRef]
- Raghavendra, A.S.; Gonugunta, V.K.; Christmann, A.; Grill, E. Aba perception and signalling. Trends Plant Sci. 2010, 15, 395–401. [Google Scholar] [CrossRef]
- Stone, S.; Williams, L.; Farmer, L.; Vierstra, R.; Callis, J. Keep on going, a ring e3 ligase essential for arabidopsis growth and development, is involved in abscisic acid signaling. Plant Cell 2007, 18, 3415–3428. [Google Scholar] [CrossRef]
- Wu, Q.; Zhang, X.; Peirats-Llobet, M.; Belda-Palazon, B.; Wang, X.; Cui, S.; Yu, X.A.-O.; Rodriguez, P.A.-O.; An, C. Ubiquitin ligases rglg1 and rglg5 regulate abscisic acid signaling by controlling the turnover of phosphatase pp2ca. Plant Cell 2016, 28, 2178–2196. [Google Scholar] [CrossRef]
- Cheng, C.; Wang, Z.; Ren, Z.; Zhi, L.; Yao, B.; Chao, S.; Liu, L.; Li, X. Scfatpp2-b11 modulates aba signaling by facilitating snrk2.3 degradation in arabidopsis thaliana. PLoS Genet. 2017, 13, e1006947. [Google Scholar] [CrossRef] [PubMed]
- Kong, L.; Cheng, J.; Zhu, Y.; Ding, Y.; Meng, J.; Chen, Z.; Xie, Q.; Guo, Y.; Li, J.; Yang, S.; et al. Degradation of the aba co-receptor abi1 by pub12/13 u-box e3 ligases. Nat. Commun. 2015, 6, 8630. [Google Scholar] [CrossRef] [PubMed]
- Seo, J.S.; Zhao, P.; Jung, C.; Chua, N.H. Plant u-box protein 10 negatively regulates abscisic acid response in arabidopsis. Appl. Biol. Chem. 2019, 62, 39. [Google Scholar] [CrossRef]
- Girod, P.-A.; Fu, H.; Zrÿd, J.-P.; Vierstra, R. Multiubiquitin chain binding subunit mcb1 (rpn10) of the 26s proteasome is essential for developmental progression in physcomitrella patens. Plant Cell 1999, 11, 1457–1472. [Google Scholar] [CrossRef] [PubMed]
- Ranjan, A.; Dickopf, S.; Ullrich, K.K.; Rensing, S.A.; Hoecker, U. Functional analysis of cop1 and spa orthologs from physcomitrella and rice during photomorphogenesis of transgenic arabidopsis reveals distinct evolutionary conservation. BMC Plant Biol. 2014, 14, 178. [Google Scholar] [CrossRef]
- Wang, J.; Liu, S.; Liu, H.; Chen, K.; Zhang, P. Pnsag1, an e3 ubiquitin ligase of the antarctic moss pohlia nutans, enhanced sensitivity to salt stress and aba. Plant Physiol. Bioch. 2019, 141, 343–352. [Google Scholar] [CrossRef]
- Guillory, A.; Bonhomme, S. Phytohormone biosynthesis and signaling pathways of mosses. Plant Mol. Biol. 2021, 107, 245–277. [Google Scholar] [CrossRef]
- Holdsworth, M.; Vicente, J.; Sharma, G.; Abbas, M.; Zubrycka, A. The plant n-degron pathways of ubiquitin-mediated proteolysis. J. Integr. Plant Biol. 2019, 62, 70–89. [Google Scholar] [CrossRef]
Publisher’s Note: MDPI stays neutral with regard to jurisdictional claims in published maps and institutional affiliations. |
© 2022 by the authors. Licensee MDPI, Basel, Switzerland. This article is an open access article distributed under the terms and conditions of the Creative Commons Attribution (CC BY) license (https://creativecommons.org/licenses/by/4.0/).







